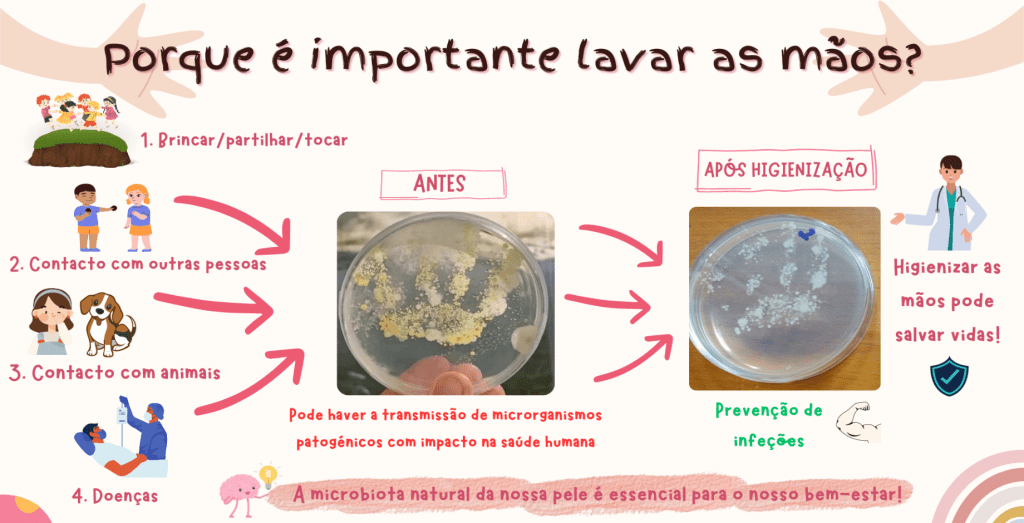
Micróbios nas nossas&nbsp;mãos?

Categoria: higienização
-
Micróbios nas nossas mãos?
Lavar as mãos é importante para manter o equilíbrio da microbiota da pele, eliminando microrganismos que causam doenças! “Micróbios nas nossas mãos?” Sabias que a microbiota da pele, ou seja, o conjunto de microrganismos que habitam a nossa pele, é essencial para o nosso bem-estar? Sim, aqueles organismos microscópicos que não consegues visualizar a olho…
